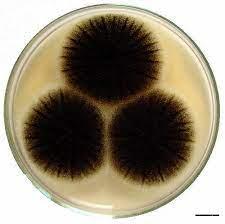
0cbea821-f428-4a5b-bb76-12dd660700cb

10) Houby
Created by Martin Krejzek

Nepohlavní rozmnožování
- Z podhoubí se tvoří různé typy nosičů nesoucích nepohlavní výtrusy
- U kvasinek pučením
Kropidlovec černavý

- Rozkládá substráty bohaté na sacharidy
- Tvoří husté šedé povlaky
Plíseň hlavičková

- Bělavé povlaky v marmeládách nebo na vlhkém chlebě
Stavba


- Buněčná stěna z chitinu
- Krom kvasinek tvoří mycelium
- Někteří zástupci tvoří plodnice
Rozmnožování

Zygomyceta (houby spájivé)

- Výživa saprofytická nebo parazitická
- Nepravidělně přehrádkované a trubicovité podhoubí
- Složka půdní mikroflóry, podílejí se na rozkladu organické hmoty
- Buněčná stěna z chitinu
Nepohlavní
- Je málo časté
- Probíhá pomocí konidií nebo fragmentací mycelia
Kvasinky
- Účastní se kvasných procesů
- Součást půdní mikroflóry
- Kvasinka pivní (Sacharomyces cerevisiae)
- Používá se k výrobě lihu , v pivovarnictví a v lékařství
- Kynutá těsta a lisované kvasinky = droždí
Pohlavní

- Bazidiospory (haploidní, pohlavně rozlišné výtrusy) klíčí v jednojaderné mycelium s výtrusy
- Dochází ke spojení mycelií v plazmogamii
- Vzniká dvojjaderné mycelium
- Za vhodných podmínek vyroste plodnice a na plodnici se vytvoří bazidiospory
Vřeckovýtrusné houby

- Tvoří vřecka, což je specializované sporangium
- Nejpočetnější skupina hub
- Převážně saprofyté
Plísně
Stavba

- Mají přehrádkové mycelium
- Na spodní straně klobouku mají póry
- Mnoho druhů vytváří barevné plodnice
- Mladé houby jsou obalené plachetkou a klouboukem (popřípadě i závojem), říká se tomu celkový obal houby
Rozmnožování

Jedovaté houby
Rzi a sněti
Mikrosporidie

- Cizopasníci bezobratlých, členovců a ryb
- Jednobuněčné organismy
- Buňka obshauje pólová vlákna = po vymrštění proniká do hostitelské buňky
Houby Stopkovýtrusné

- Převážně saprofyté
- Významní dekompozitoři
- Jejich výtrusy vznikají na koncích kyjovitých buněk zvaných bazidie
Jedlé houby
Nepohlavní rozmnožování
- Úlomky stélky (celé lišejníky)
Rakovinovec bramborový

Houby lichenizované

- Ekologicky vyhraněná skupina
- Organizmy vzniklé symbiózou houby (mykobiont), sinice nebo zelené řasy (fykobiont)
- Fykobiont poskytuje houbě organické látky, a získává od ní organické látky a vodu
- Soužití je pro oba partnery výhodné, protože si mezi sebou vyměňují důležité látky
- = přežití v nepříznivých podmínkách
Rozmnožování lišejníků

Pohlavní rozmnožování
- Rozmnožuje se pouze houba
- Tvoří různé plodnice a vřecka s výtrusy
Chytridiomycety

- Saprofyté a parazité rostlin žijící ve vodě nebo vlhké půdě
- Tělo tvořeno jednobuněčnou stélkou
- Buněčná stěna z chitinu
Stavba lišejníků

- Stavbu těla tvoří pletiva houbových vláken v nichž jsou rozptýleny buňky sinic nebo zelených řas
- K podkladu je lišejník přirostlý příchytnými vlákny
- Má 3 druhy stélek:
Metabolismus hub
- Heterotrofní organismy
- Saprofyté = rozkládají organické látky z odumřelých těl
- Parazité = berou si organické látky z živého hostitele
- Symbionti = vzájemně prospěšné soužití s jinými organismy
Stavba těla hub

- Tělo tvoří stélka (není členěno na jednotlivé orgány)
- Mnohobuněčná
- Kokální
- Vláknitá = hyfa = houbová vlákna tvořící mycelium, na kterém vyrůstají plodnice
- Jednobuněčná
- Základní stavební látkou je chitin
Hlenky

- Saprofyté nebo parazité
- Živí se fagocytózou
- Žijí na vlhkých místech
- Nevytvářejí podhoubí
- Výskyt v lesích a na tlejícím dřevě
- Vývojový cyklus:
- Jednobuněčné haploidní myxoaméby (nahé bky) nebo myxomonády (buňky s bičíky)
- Mnohojaderné diploidní plazmodium
- Rozmnožování:
- Pohlavním splynutím dvou myxoaméb a myxomonád
- Kulovitý výtrus naboptná a praskne > vyrůstají myxoaméby nebo myxomonády > rozmnožují se dělením = pohlavní splynutí 2 myxoaméb nebo myxomonád > vzniká diploidní zygota > splýváním zygot vznikne mladé plazmodium > na zralém plazmodiu se vytvoří výtrusnice s haploidními výtrusy
- Vlčí mléko = vytváří červená kulovitá plazmodia, která později s tvorbou výtrusu získávají fialovošedivou barvu
10) Houby

- Eukaryotní organismy
- Zásobní látkou je glykogen a buněčná stěna je s B glukanu
Význam hub pro člověka

- Složka potravy
- Výroba chleba, kynutého pečiva a alkoholu
- Biotechnologie = výroba antibiotik a vitamínů
Rozmnožování hub

Význam hub v přírodě

- Dekompozitoři
- Jsou důležité při tvorbě humusu
- Jsou však nejbohatším původcem chorob u rostlin a živočichů
Hyfy = houbová vlákna
Mycelium = podhoubí
- Vzniká srůstem hyf
- Vyrůstají zde plodnice
Pseudomycelium = nepravé podhoubí
Nepohlavní rozmnožování
- Především u parazitických hub
Pučením
- U kvasinek
- Růst dceřinné buňky z buňky mateřské
Výtrusy
- Na sporangiích nebo na houbových vláknech kondioforech
Pohlavní rozmnožování
- U většiny druhů hub
- Dochází k němu jednou ročně
- Vytvoří se spory v plodnicích a poté se uvolňují
Systematika hub
Rozmnožování chydridiomycet
- V životním cyklu převládá haploidní fáze, kterou představují:
Zoospory
- Vytvářejí se ve sporangiu
- Jsou pohyblivé
- Rozmnožují se nepohlavně
Gamety
- Vytváří se ze zoospor
- Splyutím 2 gamet vzniká zygota
- Jsou pohybůivé
Hmyzomorka včelí

- Parazituje v trávicím ústrojí včely medonosné
Rozmnožování zygomycet
Nepohlavní rozmnožování
- Probíhá pomocí sporangiospor (nepohlavních výtrusů), vznikajících ve výtrusnicích (sporangiích) na sporangioforech
Pohlavní rozmnožování
Spájením


- Nastává spájením dvou různopohlavních hyf (+ a -) > dotykem se oddělí přehrákami od ostatního podhoubí a přemění se v gametangia > gametangia splynou v diploidní zygotu a vytvoří se zygospora > zygospora se uvolní z podhoubí a klíčí v sporangiofor zakončený výtrusnicí (sparangiem), v němž vznikají haploidní výtrusy
Zástupci
Rozmnožování kvasinek
Nepohlavní rozmnožování
- Je rychlejší
- Probíhá za příznivých podmínek
Pučením
- Na mateřské buňce vyrůstá pupen a vznikne dceřinná buňka
- Dceřinná buňka se oddělí a zůstává po ní jizva
- Když ne, tvoří se řetízky (nepravé mycelium)
Pohlavní rozmnožování
- Nastává při nedostatku živin v prostředí
Proces
- Ve zvětšených buňkách proběhne meotické dělení
- V každém vřecku vzniknou 4 haploidní výtrusy (2+ a 2-)
- Po prasknutí vřecka se výtrusy uvoní a za příznivých podmínek začnou klíčit v buňky
- Dvě rozličné buňky (+ a -) splývají v diploidní zygotu, která pučením vytvoří nové buňky
Štětičkovec

Kropidlák černý
- Je to černá plíseň na ovoci a zelenině
Lanýž černý
- Má podzemní plodnice
- Vzácná aromatická houba
Zástupci
Mochomůrka zelená

Mochomůrka tygrovaná
Závojenka olovová

Rez travní

Sněť kukuřičná

Hřib hnědý

Hřib smrkový

Kozák březový

Dřevokazné houby
- Parazité nebo saprofyté
- Schopnost rozkládat dřevo
Choroš domácí
Václavka obecná

Hlíva ústřičná

Druhy stélek
Korovitá
- Celou spodní stranou přirůstá k podkladu
Lupenitá
- Rozprostřená do plochy, volné laločnaté okraje
Keříčkovitá
- Větvená, upevněná v jednom místě
Pohlavní rozmnožování

- V podhoubí se tvoří samčí = kyjovitá anetangia a samičí = zeptat se mnohojaderná askogonia pohlavní orgány
- Orgány se přitahují k sobě, buněčné stěny se rozpouštějí
- Obsah samčího orgánu přechází do orgánu samičího
- Tato fáze se nazývá plazmogomie
- Poté dochází ke splynutí samčích a samičích jader
- Tvoří se kyjovitá vřecka
- Diploidní jádra ve vřecku prochází meiózou nebo mitózou
- Vzniká 8 - zeptat se haploidních jader, které e přemění na výtrusy
Životní cyklus
- V životním cyklu převažuje dvoujaderné podhoubí, které vzniká splynutí + a - podhoubí
- Při plynutí dochází ke splynutí buněčn plazmy
- Dvoujaderné podhoubí roste neomezeně dlouho a za příhodných podmínek tvoří plodnice
Mykorhiza
- Soužití kořenů vyšších rostlin a podhoubí některých hub
Endotrofní
- Vlákna podhoubí vznikají až do buněk kořínků
Ektotrofní
- Hyfy obsahují nejmenší kořínky rostlin
UDĚLAT NOV PREZENTACI S DALŠÍMI SLIDY